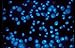

Whatman 7063-2504 Filter Circles, 25mm Dia, Cyclopore Track-Etched Pol
Gallery
Attributes
Distributor offers
| Seller | SKU | MOQ | In stock | Multiple | Prices |
|---|---|---|---|---|---|
| 7063-2504 | 1 | -2 | 1 | 1 @ $153.00 | |
| Amazon | B00U1N4Y4E | -3 | 1 @ $95.25 |
Related on Amazon
As an Amazon Associate, we earn from qualifying purchases. (paid link) CERTAIN CONTENT THAT APPEARS ON THIS SITE COMES FROM AMAZON. THIS CONTENT IS PROVIDED 'AS IS' AND IS SUBJECT TO CHANGE OR REMOVAL AT ANY TIME.

Whatman 7063-2504 Black Polycarbonate Cyclopore Track-Etched Membrane Filters, 25mm Diameter, 0.4 Micron (Pack of 100)
Brand: Whatman
Details
- Diameter: 25mm; pore size: 0.4µm
- Ideal for epifluorescence and other microscopy applications requiring a contrasting background
- Polycarbonate membrane is used to filter the sample and is then used directly for analysis
- Dark membrane gives lower background fluorescence and improves the sensitivity of the test
- Manufactured to produce a precision membrane filter with a closely controlled pore size distribution
Listing
| Binding | Misc. |
|---|---|
| Product group | BISS Basic |
| Product type | LAB_SUPPLY |
| Model | WHA-7063-2504 |
| Part number | 7063-2504 |
| Items per pack | 100 |
| Label | Whatman |
| Manufacturer | Whatman |
Catalog
| Feature | Diameter: 25mm; pore size: 0.4\xb5m |
|---|---|
| Category | Industrial & Scientific |
| MPN | 7063-2504 |
| Product group | BISS |
| Product type | LAB_SUPPLY |
| Manufacturer | Whatman |
Whatman 7063-2504 Cyclopore Polycarbonate Membrane, BL 25 mm 0.4 um (Pack of 100)
Brand: Whatman
Details
- Low affinity for stains provides higher optical contrast and makes visibility under a microscope easy
- True surface capture provides easy examination of samples and short analysis times
- Totally transparent membranes available
- Negligible absorption and adsorption of filtrate; no hygroscopic
- Low tare weights
Listing
| Binding | Misc. |
|---|---|
| Product group | BISS |
| Product type | LAB_SUPPLY |
| Model | 7063-2504 |
| Part number | 7063-2504 |
| Items per pack | 100 |
| Label | GE Healthcare |
| Manufacturer | GE Healthcare |
GE Healthcare 7063-2504 Whatman Cyclopore Membrane Filters, Circle, 0.4 µm Pore Size, 25 mm Diameter, Polycarbonate, Black (Pack of 100)
Brand: Whatman
Details
- Low affinity for stains improves visibility under a microscope
- Low protein binding minimizes sample loss of proteinaceous samples
- Narrow pore size distribution and high pore density support rapid surface capture of analytic
- Negligible absorption and adsorption of filtrate; nonhygroscopic
- No particle shedding enables clean filtrate